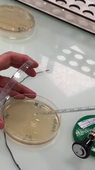
film ensemencements.MOV

Nous utilisons des cookies pour personnaliser l’affichage (barre de menu de droite, mode sombre ou dyslexie etc.), gérer la session (authentification) et analyser le trafic du site (pour certaines instances).
En savoir plus
Nous utilisons des cookies pour personnaliser l’affichage (barre de menu de droite, mode sombre ou dyslexie etc.), gérer la session (authentification) et analyser le trafic du site (pour certaines instances).
En savoir plus